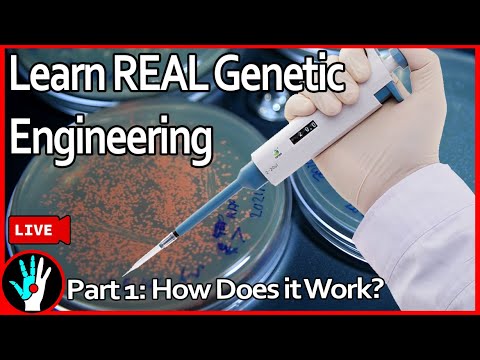
[LIVE] Learn Genetic Engineering - Part 1: How does it work?

Rewriting DNA to make custom monstrosities
The Thought Emporium
View ChannelAbout
Science is a bottomless well of some of the most amazing things this universe has to offer. There is so much amazing science and engineering that gets done, but most often the only ones who get to experience it first hand are those in expensive labs in universities. This channel aims to explore as much of fields of science and engineering as possible by showing real experiments and research being done in a fun and accessible way. While the goal is to show that even very hard science can be done in a DIY way, some projects will use some of the fancier toys that while less accessible, opens a broader range of projects that can be done. We cover everything from genetic engineering and tissue culture, to nuclear physics, to machine engineering, to chemical synthesis and more.
Latest Posts
No Recommendations Found
No products were found for the selected channel.